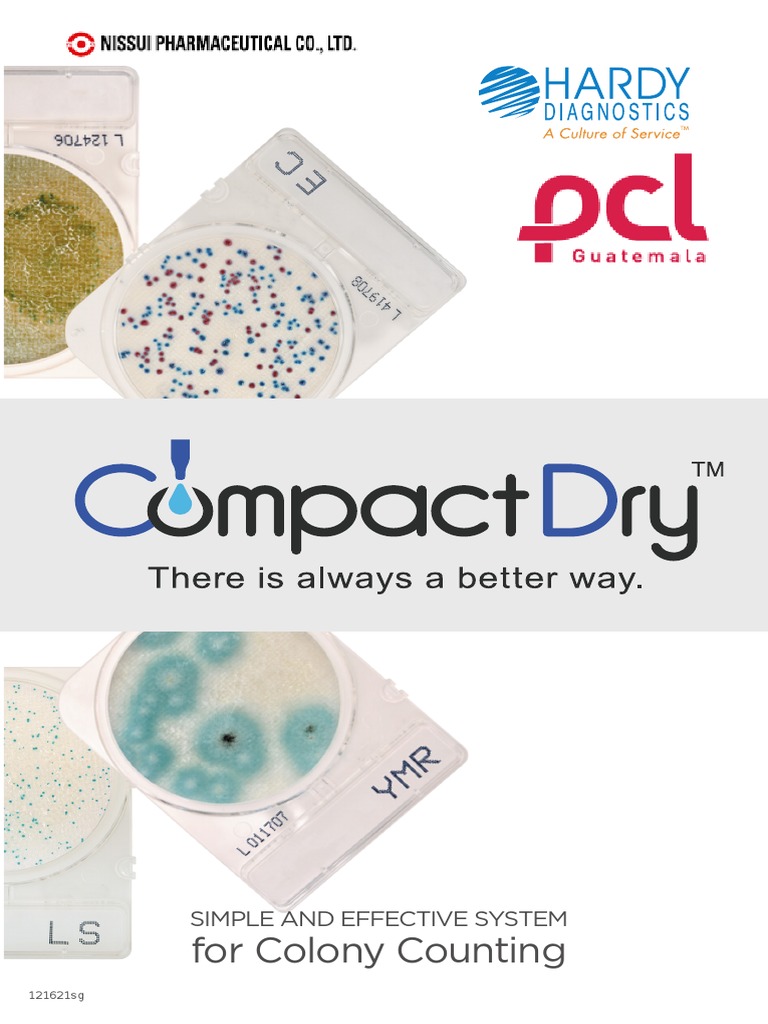

Dri Catalog
Dri Catalog - You have to believe that the hard work you put in at the beginning will pay off, even if you can't see the immediate results. It requires a leap of faith. This means user research, interviews, surveys, and creating tools like user personas and journey maps. " While we might think that more choice is always better, research shows that an overabundance of options can lead to decision paralysis, anxiety, and, even when a choice is made, a lower level of satisfaction because of the nagging fear that a better option might have been missed. We will begin with the procedure for removing the main spindle assembly, a task required for bearing replacement. Creativity is stifled when the template is treated as a rigid set of rules to be obeyed rather than a flexible framework to be adapted, challenged, or even broken when necessary. The printable chart, in turn, is used for what it does best: focused, daily planning, brainstorming and creative ideation, and tracking a small number of high-priority personal goals. The animation transformed a complex dataset into a breathtaking and emotional story of global development. This makes the printable an excellent tool for deep work, study, and deliberate planning. These lights illuminate to indicate a system malfunction or to show that a particular feature is active. Facades with repeating geometric motifs can create visually striking exteriors while also providing practical benefits such as shading and ventilation. Your first step is to remove the caliper. While digital planners offer undeniable benefits like accessibility from any device, automated reminders, and easy sharing capabilities, they also come with significant drawbacks. The "disadvantages" of a paper chart are often its greatest features in disguise. To be printable no longer refers solely to rendering an image on a flat sheet of paper; it now means being ableto materialize a physical object from a digital blueprint. It was about scaling excellence, ensuring that the brand could grow and communicate across countless platforms and through the hands of countless people, without losing its soul. Finally, reinstall the two P2 pentalobe screws at the bottom of the device to secure the assembly. Market research is essential to understand what customers want. Digital tools are dependent on battery life and internet connectivity, they can pose privacy and security risks, and, most importantly, they are a primary source of distraction through a constant barrage of notifications and the temptation of multitasking. Beginners often start with simple projects such as scarves or dishcloths, which allow them to practice basic stitches and techniques. 16 A printable chart acts as a powerful countermeasure to this natural tendency to forget. A design system is essentially a dynamic, interactive, and code-based version of a brand manual. From a simple plastic bottle to a complex engine block, countless objects in our world owe their existence to this type of industrial template. It contains important information, warnings, and recommendations that will help you understand and enjoy the full capabilities of your SUV. A low or contaminated fluid level is a common cause of performance degradation. Your Toyota Ascentia is equipped with Toyota Safety Sense, an advanced suite of active safety technologies designed to help protect you and your passengers from harm. 26 For both children and adults, being able to accurately identify and name an emotion is the critical first step toward managing it effectively. This requires the template to be responsive, to be able to intelligently reconfigure its own layout based on the size of the screen. It taught me that creating the system is, in many ways, a more profound act of design than creating any single artifact within it. It is a liberating experience that encourages artists to let go of preconceived notions of perfection and control, instead embracing the unpredictable and the unexpected. This act of circling was a profound one; it was an act of claiming, of declaring an intention, of trying to will a two-dimensional image into a three-dimensional reality. Similarly, an industrial designer uses form, texture, and even sound to communicate how a product should be used. This gallery might include a business letter template, a formal report template, an academic essay template, or a flyer template. Advances in technology have expanded the possibilities for creating and manipulating patterns, leading to innovative applications and new forms of expression. It is the pattern that precedes the pattern, the structure that gives shape to substance. Pay attention to proportions, perspective, and details. A good search experience feels like magic. This digital foundation has given rise to a vibrant and sprawling ecosystem of creative printables, a subculture and cottage industry that thrives on the internet. The entire system becomes a cohesive and personal organizational hub. Spreadsheets, too, are a domain where the template thrives. In this format, the items being compared are typically listed down the first column, creating the rows of the table. I was being asked to be a factory worker, to pour pre-existing content into a pre-defined mould. For example, an employee at a company that truly prioritizes "Customer-Centricity" would feel empowered to bend a rule or go the extra mile to solve a customer's problem, knowing their actions are supported by the organization's core tenets. Creativity is stifled when the template is treated as a rigid set of rules to be obeyed rather than a flexible framework to be adapted, challenged, or even broken when necessary. It is a set of benevolent constraints, a scaffold that provides support during the messy process of creation and then recedes into the background, allowing the final, unique product to stand on its own. Each technique can create different textures and effects. Proceed to unbolt the main spindle cartridge from the headstock casting. We can never see the entire iceberg at once, but we now know it is there. It feels like an attack on your talent and your identity. It is not a passive document waiting to be consulted; it is an active agent that uses a sophisticated arsenal of techniques—notifications, pop-ups, personalized emails, retargeting ads—to capture and hold our attention. The chart is a brilliant hack. The educational sphere is another massive domain, providing a lifeline for teachers, homeschoolers, and parents. The first is the danger of the filter bubble. I just start sketching, doodling, and making marks. A beautiful chart is one that is stripped of all non-essential "junk," where the elegance of the visual form arises directly from the integrity of the data. That humble file, with its neat boxes and its Latin gibberish, felt like a cage for my ideas, a pre-written ending to a story I hadn't even had the chance to begin. It’s an acronym that stands for Substitute, Combine, Adapt, Modify, Put to another use, Eliminate, and Reverse. The Aura Grow app will send you a notification when the water level is running low, ensuring that your plants never go thirsty. 21 The primary strategic value of this chart lies in its ability to make complex workflows transparent and analyzable, revealing bottlenecks, redundancies, and non-value-added steps that are often obscured in text-based descriptions. These aren't meant to be beautiful drawings. 23 This visual evidence of progress enhances commitment and focus. It reduces mental friction, making it easier for the brain to process the information and understand its meaning. The question is always: what is the nature of the data, and what is the story I am trying to tell? If I want to show the hierarchical structure of a company's budget, breaking down spending from large departments into smaller and smaller line items, a simple bar chart is useless. For management, the chart helps to identify potential gaps or overlaps in responsibilities, allowing them to optimize the structure for greater efficiency. A designer using this template didn't have to re-invent the typographic system for every page; they could simply apply the appropriate style, ensuring consistency and saving an enormous amount of time. This article delves into the multifaceted benefits of journaling, exploring its historical significance, psychological impacts, and practical applications in today's fast-paced world. The division of the catalog into sections—"Action Figures," "Dolls," "Building Blocks," "Video Games"—is not a trivial act of organization; it is the creation of a taxonomy of play, a structured universe designed to be easily understood by its intended audience. Forms are three-dimensional shapes that give a sense of volume. We see it in the rise of certifications like Fair Trade, which attempt to make the ethical cost of labor visible to the consumer, guaranteeing that a certain standard of wages and working conditions has been met. If the 19th-century mail-order catalog sample was about providing access to goods, the mid-20th century catalog sample was about providing access to an idea. There is a growing recognition that design is not a neutral act. The intended audience for this sample was not the general public, but a sophisticated group of architects, interior designers, and tastemakers. Educators use drawing as a tool for teaching and learning, helping students to visualize concepts, express their ideas, and develop fine motor skills. This is why taking notes by hand on a chart is so much more effective for learning and commitment than typing them verbatim into a digital device. We can never see the entire iceberg at once, but we now know it is there. These advancements are making it easier than ever for people to learn to knit, explore new techniques, and push the boundaries of the craft. To reattach the screen assembly, first ensure that the perimeter of the rear casing is clean and free of any old adhesive residue. My initial reaction was dread.Request a FREE Catalog DR Power Equipment
What a season! Find the perfect inspiration for your wardrobe look at
Catalog Dr. Max Hiper oferte ianuarie 2025 Oferte Catalog
DriDesign, product catalog ArchDaily
Catalog Dr. Max Farmacie iunie 2024 Oferte Catalog
DriDesign, product catalog ArchDaily
2024 ROCHAIN DR CATALOG PDF
Catalog Dr. Max Proximitate septembrie 2023 Oferte Catalog
Fall 2022 Dr. Leonard's
Catalog Dr Max Sanatate Iunie Iulie August 2024 Catalog AZ
Nike MLB DriFit One Button Jerseys
(PDF) Predstavitveni katalog DRI DOKUMEN.TIPS
CR DR Catalog Download Free PDF Imaging Computer Engineering
Ein Blick in den neuen ProWINKatalog 2025 Innovation trifft
ONLINE CATALOGS Elite Graphics
Catalog Dr.Max Oferte de la 01.03.2025
OilDri Catalog v.17 PDF Occupational Safety And Health
DR Catalog PDF
Free 2024 dr leonard s healthcare catalog request Artofit
Dri Gear Reflex Polo
BADGR LDY BDRI S/S PERF T ACC Website
Catalog Dr. Max Farmacie octombrie 2024 Oferte Catalog
Catalog Dr. Max Farmacie aprilie 2024 Oferte Catalog
Catalog Dr. Max Proximitate octombrie 2023 Oferte Catalog
Product Documentation
Request a FREE Catalog DR Power Equipment
Dried Fruit Catalog Design on Behance
Product Documentation
Buy Nike DriFit Miler DriFit Miler Running Shirt Men Olive online
Compact Dry Catalog 2022 PDF Filtration Microbiology
CFCCDR Catalog PDF
Product Catalog DRISTEEM
Catalog Dr. Max Hiper oferte mai 2025 Oferte Catalog
Nike DriFIT 3/4 Baseball Sleeve Top SportChek
Related Post:














:quality(65)/ro/data/93/37572/0.jpg?t=1740989263)